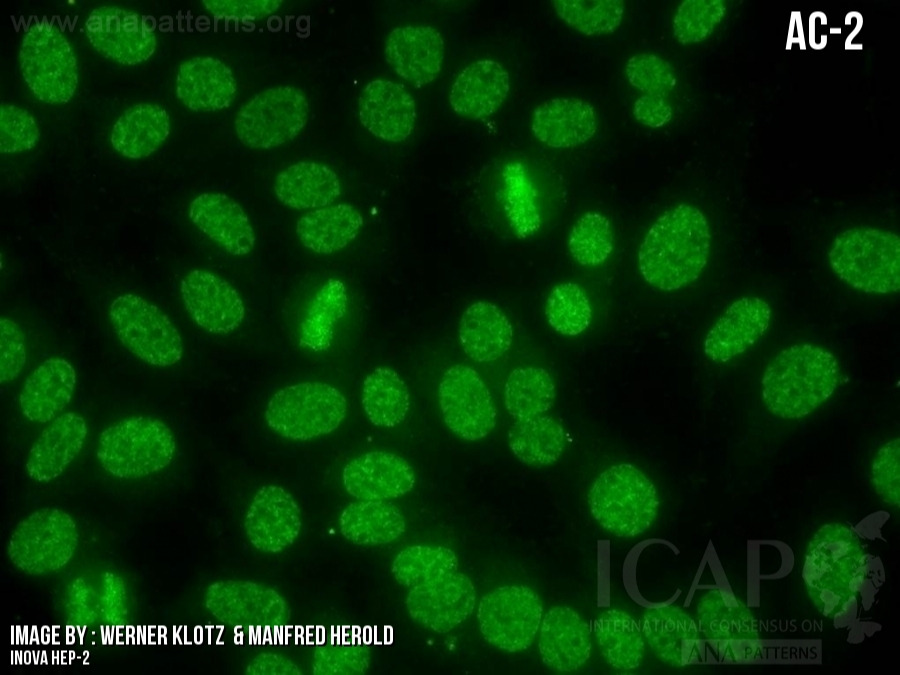
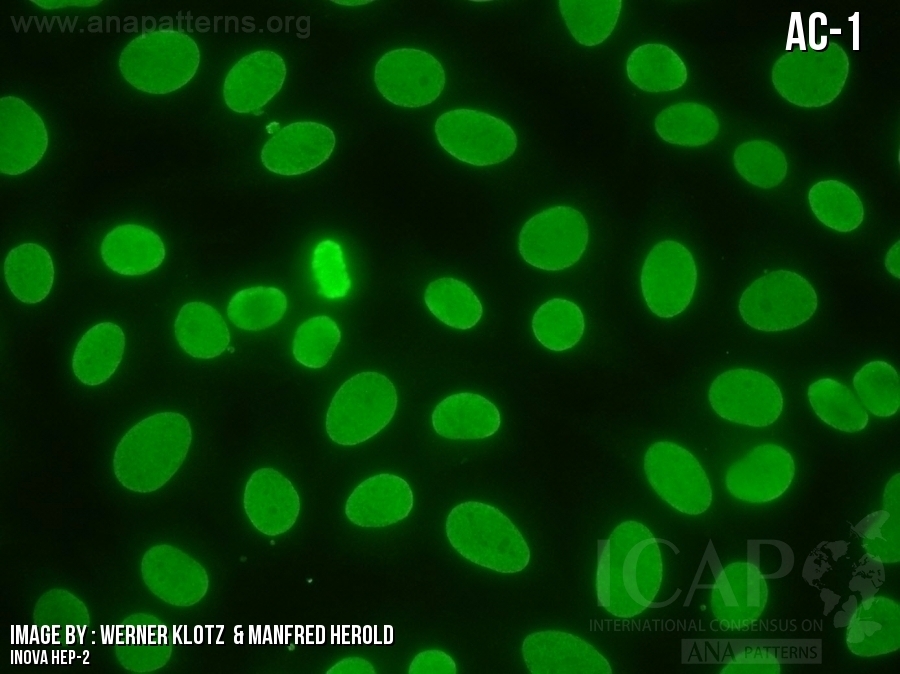

ANA Test
DFS pattern from ANA Patterns. Dense fine speckled pattern is strongly associated with a false positive ANA and usually not found with autoimmune disease like lupus, scleroderma or Sjogren syndrome.
Negative ANA Pattern from ANA Patterns

Nucleolar pattern from ANA Patterns

Homo pattern from ANA Patterns
Centromere Pattern from ANA Patterns

Cytoplasmic pattern from ANA Patterns

ANA is often a red herring. Red herring = something, especially a clue, that is or is intended to be misleading or distracting. (Oxford Languages) .
How to order

[1]
Luis E.C. Andrade et al. Reflecting on a decade of the international consensus on ANA patterns (ICAP): Accomplishments and challenges from the perspective of the 7th ICAP workshop, Autoimmunity Reviews, Volume 23, Issue 9, 2024
https://doi.org/10.1016/j.autrev.2024.103608.
(https://www.sciencedirect.com/science/article/pii/S1568997224000995)
Lorem ipsum dolor sit amet, consectetur adipisicing elit. Maiores ipsum repellat minus nihil. Labore, delectus, nam dignissimos ea repudiandae minima voluptatum magni pariatur possimus quia accusamus harum facilis corporis animi nisi. Enim, pariatur, impedit quia repellat harum ipsam laboriosam voluptas dicta illum nisi obcaecati reprehenderit quis placeat recusandae tenetur aperiam.